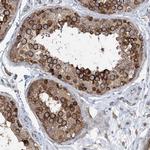
LAR4B Antibody in Immunohistochemistry (Paraffin) (IHC (P))

Search
Invitrogen
LAR4B Polyclonal Antibody
{{$productOrderCtrl.translations['antibody.pdp.commerceCard.promotion.promotions']}}
{{$productOrderCtrl.translations['antibody.pdp.commerceCard.promotion.viewpromo']}}
{{$productOrderCtrl.translations['antibody.pdp.commerceCard.promotion.promocode']}}: {{promo.promoCode}} {{promo.promoTitle}} {{promo.promoDescription}}. {{$productOrderCtrl.translations['antibody.pdp.commerceCard.promotion.learnmore']}}
产品信息
PA5-57721
种属反应
宿主/亚型
分类
类型
抗原
偶联物
形式
浓度
规格
纯化类型
保存液
内含物
保存条件
运输条件
RRID
产品详细信息
Immunogen sequence: FENRLSSLII GPSKERTLSA DASVNTLPVV VSREPSVPAS CAVSATYERS PSPAHLPDDP KVAEKQRETH SVDRLPSALT ATACKSVQVN
Highest antigen sequence identity to the following orthologs: Mouse - 82%, Rat - 83%.
靶标信息
The LAR4B gene, more accurately referred to as LARP4B (La Ribonucleoprotein Domain Family Member 4B), is associated with RNA-binding proteins that are crucial for various aspects of RNA metabolism, including RNA stabilization, translation, and cellular stress responses. LARP4B belongs to the La-related protein family, which plays significant roles in maintaining RNA stability and enhancing translation efficiency of certain mRNAs. It has been identified as a target in cancer research due to its involvement in tumor biology, particularly regulating tumor suppressive pathways and interacting with microRNA networks. Studies have shown that LARP4B expression is downregulated in prostate cancer tissues, indicating its potential role as a tumor suppressor. Moreover, it is linked with liver cancer and survival rates, reflecting its importance in cellular growth and proliferation. The regulation of LARP4B and its interactions with other cellular components underline its potential therapeutic implications for cancer treatment.
仅用于科研。不用于诊断过程。未经明确授权不得转售。
篇参考文献 (0)
生物信息学
蛋白别名: KIAA0217; La ribonucleoprotein domain family member 4B; La ribonucleoprotein domain family member 5; La ribonucleoprotein domain family, member 5; La-related protein 4B; La-related protein 5
基因别名: KIAA0217; LARP4B; LARP5
UniProt ID: (Human) Q92615
Entrez Gene ID: (Human) 23185